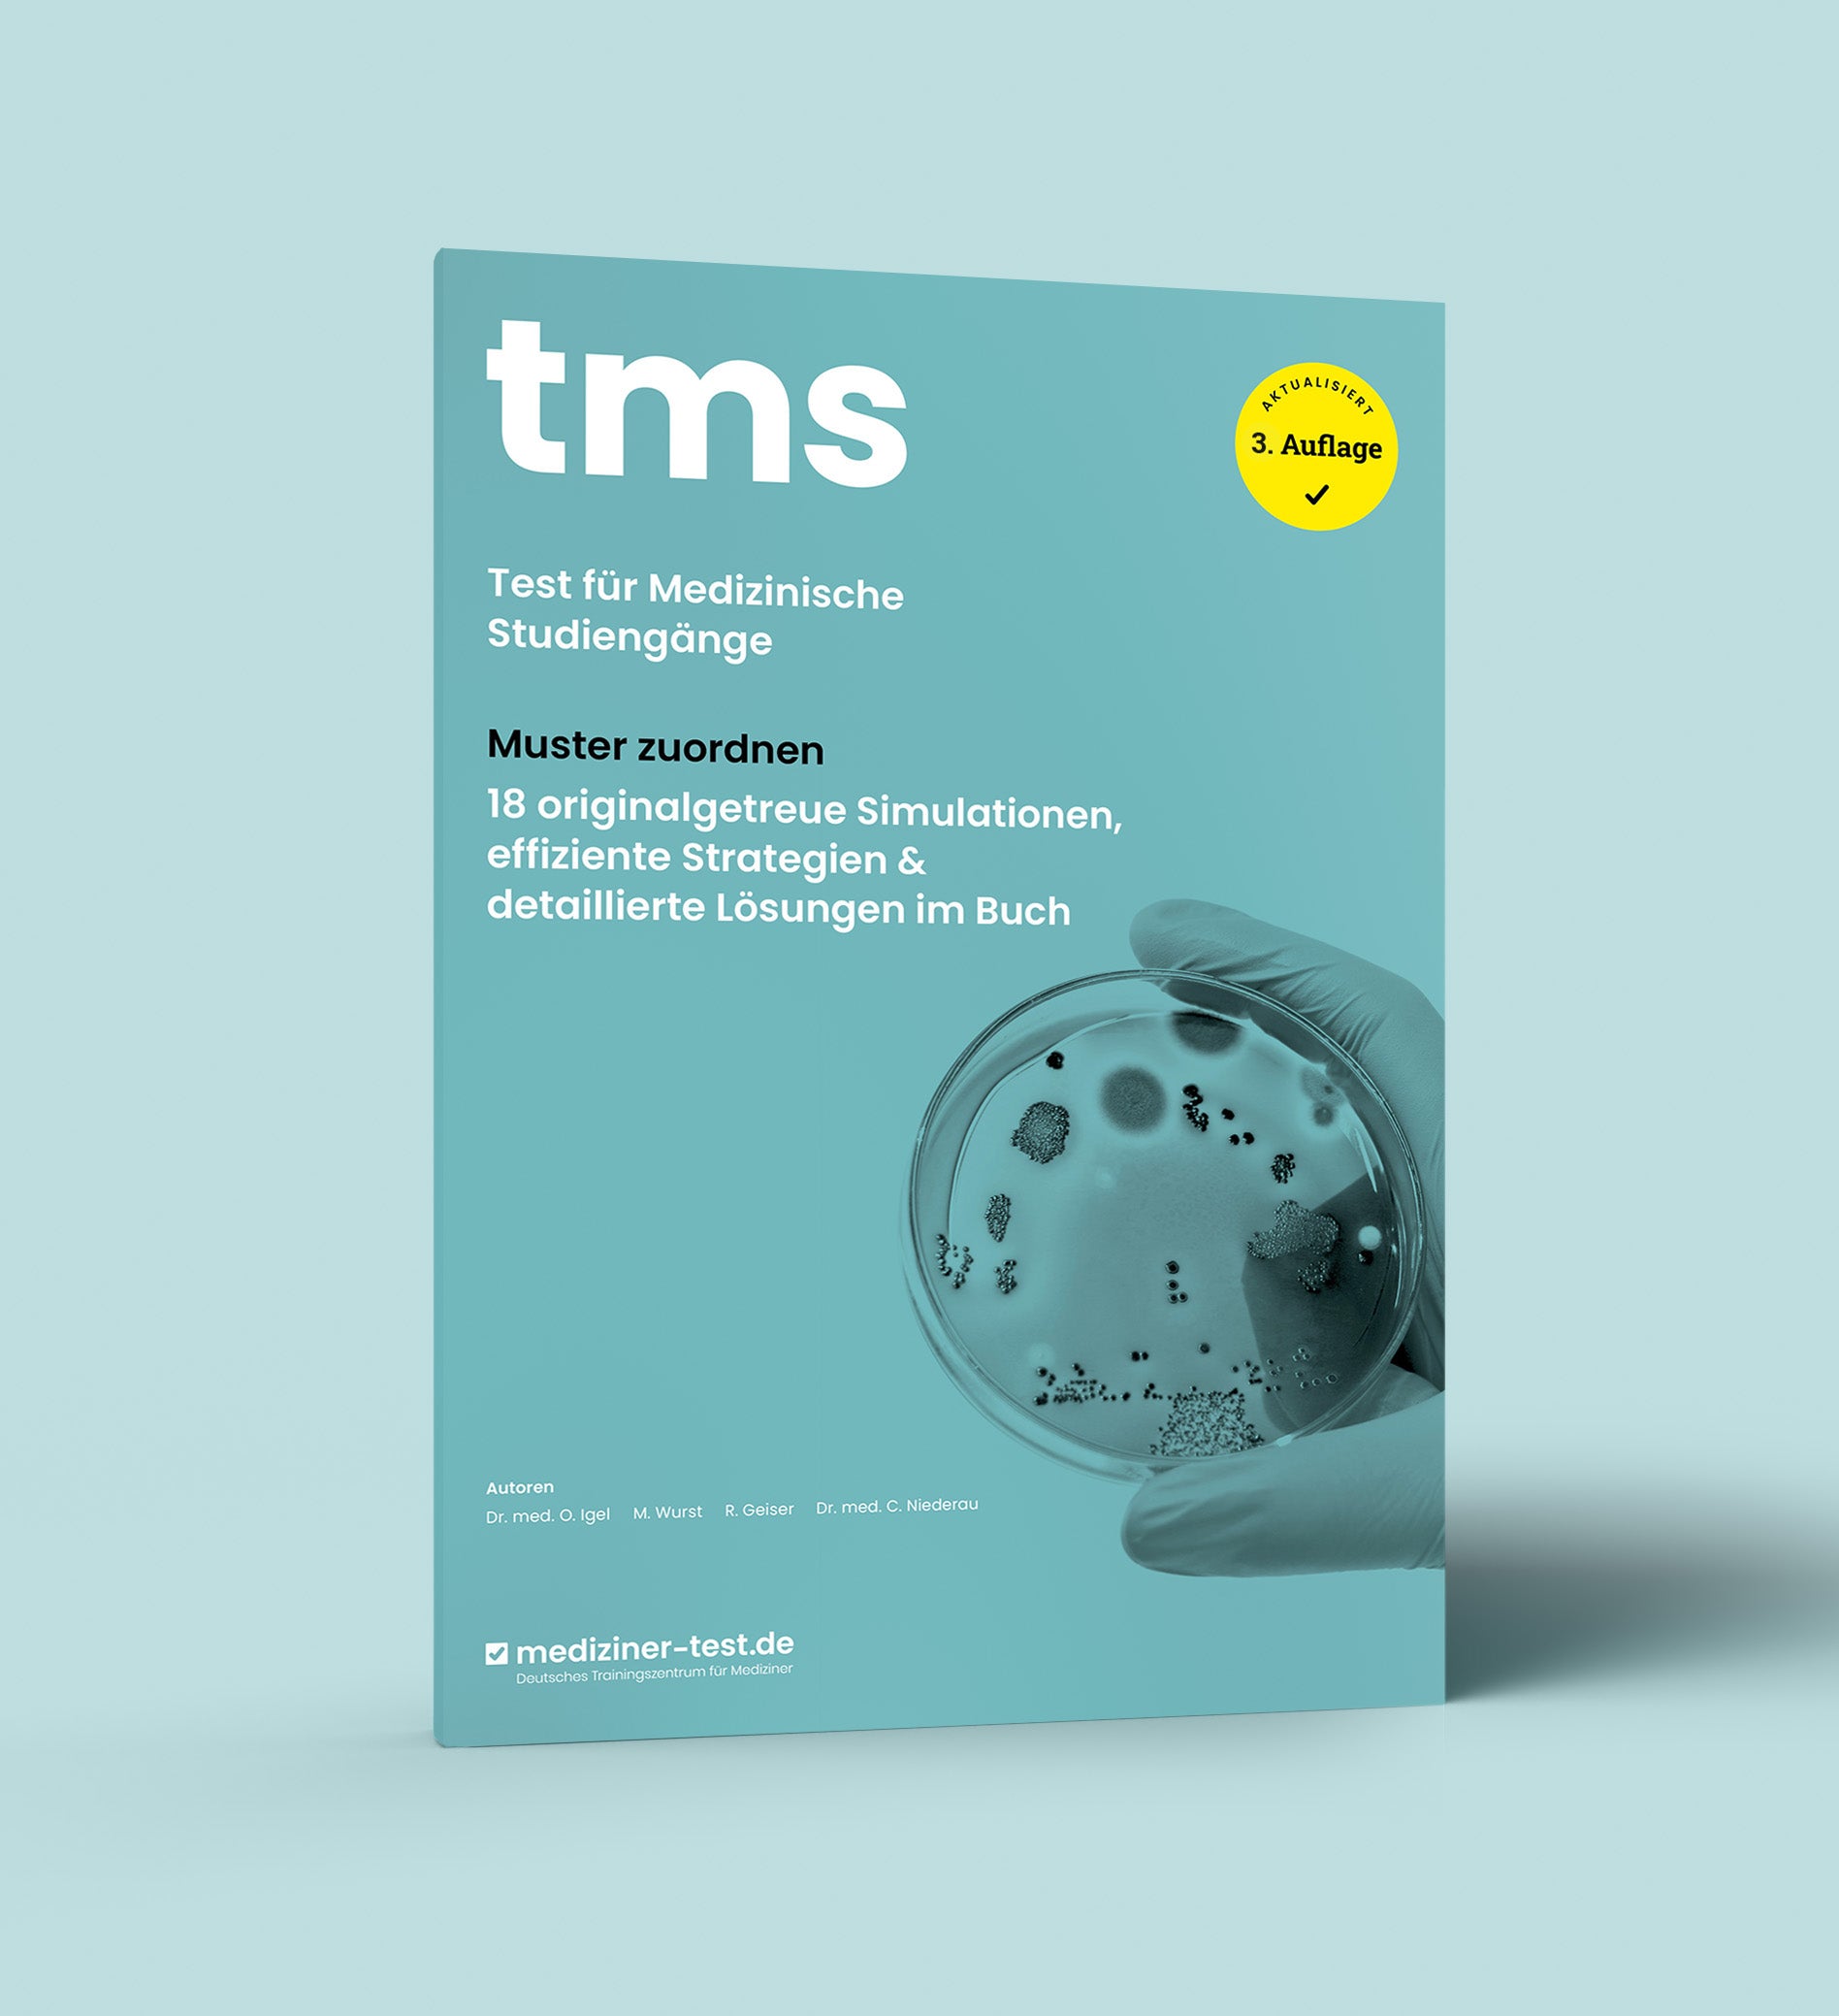

Warum die TMS-Buchreihe von mediziner-test.de?
Warum die TMS-Buchreihe von mediziner-test.de?
Die brandneue TMS-Buchreihe von mediziner-test.de ist dein Rundumpaket zur Vorbereitung auf den Medizinertest. Das alles erwartet dich in deiner TMS-Buchreihe von mediziner-test.de:
- Die TMS-Buchreihe umfasst 8 Bücher mit insgesamt fast 2.000 Seiten: Für jeden Untertest bekommst du ein Buch mit einem erstklassigem Strategieteil, hochaktuellen Simulationen sowie detaillierten Lösungen direkt im Buch. Zusätzlich enthält die Buchreihe ein Buch mit einer originalgetreuen Testsimulation auf aktuellem TMS-Niveau und wertvollen Tipps zum TMS.
- Bewährte Strategien einfach und verständlich erklärt: Im Strategieteil der jeweiligen Bücher lernst du die besten Strategien kennen, mit denen du dein Ergebnis in den Untertests deutlich steigern wirst.
- Aufsteigender Schwierigkeitsgrad - perfekt für jede Trainingssituation: Die Aufgaben sind als Simulationen mit aufsteigendem Schwierigkeitsgrad angeordnet: Du kannst damit gut ins Training starten, auf TMS-Niveau trainieren oder dich mit "harten Aufgaben" herausfordern.
- Hilfreiche Lösungskommentare direkt im Buch: In bisherigen TMS-Büchern wurde oft bemängelt, dass es keine Lösungskommentare gibt oder diese zu knapp ausfallen und nicht hilfreich sind, denn was hilft es zu wissen, dass (B) richtig ist - wenn man nicht weiß warum. Das haben wir uns zu Herzen genommen und detaillierte und verständliche Lösungskommentare entwickelt, wie du sie nirgends sonst finden wirst.
- Höchster Qualitätsanspruch für beste Ergebnisse: Die Aufgaben wurden von unserem 18-köpfigen Team in einem mehrstufigen Prozess erschafft und evaluiert, um dir die bestmögliche Qualität zu bieten. Zudem haben wir die Buchreihe von 60 Beta-Testern auf Herz und Nieren prüfen lassen und das wertvolle Feedback eingearbeitet, um die Buchreihe noch besser zu machen.
- Einzigartiges Team mit viel Herzblut und Erfahrung: Für die Erstellung der Buchreihe ist es uns gelungen, die "Urgesteine" der TMS-Szene, erfolgreiche TMS-Trainer:innen und -Coaches und motivierte Medizinstudent:innen zusammenzubringen, um unseren Anspruch - die beste TMS-Buchreihe zu erschaffen - gerecht zu werden.
Feedbacks zu unserer TMS-Buchreihe
Was ist in der TMS-Buchreihe alles enthalten?
Was ist in der TMS-Buchreihe alles enthalten?
In der TMS-Buchreihe von mediziner-test.de sind die folgenden 8 Bücher enthalten, die dich deinem Traumstudienplatz näher bringen werden:
- Muster zuordnen: insgesamt 432 Aufgaben in 18 Simulationen mit je 24 Aufgaben
- Medizinisch-naturwissenschaftliches Grundverständnis: insgesamt 144 Aufgaben in 6 Simulationen mit je 24 Aufgaben
- Schlauchfiguren: insgesamt 384 Aufgaben in 16 Simulationen mit je 24 Aufgaben
- Quantitative und formale Probleme: insgesamt 168 Aufgaben in 7 Simulationen mit je 24 Aufgaben
- Figuren und Fakten lernen: insgesamt 1.280 Aufgaben in jeweils 32 Simulationen pro Untertest mit je 20 Aufgaben
- Textverständnis: insgesamt 216 Aufgaben in 9 Simulationen mit je 24 Aufgaben
- Diagramme und Tabellen: insgesamt 144 Aufgaben in 6 Simulationen mit je 24 Aufgaben
- Eine vollständige Testsimulation mit allen Untertests: insgesamt 184 Aufgaben
Und das alles zum besten Preis-Leistungs-Verhältnis auf dem gesamten Markt – weil wir wollen, dass deine Vorbereitung bezahlbar bleibt!
TMS-Buchreihe 2026 (3. Auflage)
-
Kostenfreier Versand
Dich durch die Türen deiner Wunschuniversität gehen zu sehen - das ist unsere Motivation!
Bei der Bewerbung um einen Studienplatz in den Fächern Human-, Zahn- und Tiermedizin spielt der Test für Medizinische Studiengänge (TMS) eine immer wichtigere Rolle. Unsere TMS-Buchreihe bereitet dich umfassend auf den TMS vor und ist dein Schlüssel auf dem Weg zum bestmöglichen TMS-Ergebnis.
Unsere TMS-Buchreihe besteht aus insgesamt 8 Bänden inklusive einer originalgetreuen Testsimulation:
Band 1: Testsimulation & allgemeine Infos
Band 2: Muster zuordnen
Band 3: Medizinisch-naturwissenschaftliches Grundverständnis
Band 4: Schlauchfiguren
Band 5: Quantitative & formale Probleme
Band 6: Figuren lernen & Fakten lernen
Band 7: Textverständnis
Band 8: Diagramme & Tabellen
Enthalten sind Erfolgsstrategien, Tipps und Tricks, insgesamt fast 3.000 originalgetreue Übungsaufgaben in 94 Simulationssets zu den einzelnen Untertests sowie ausführliche Lösungskommentare!
Das alles bekommst du zum fairen Preis von 139 € - denn wir wollen, dass jede:r die Chance auf eine optimale Vorbereitung hat!